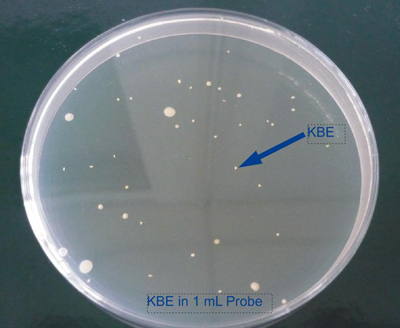
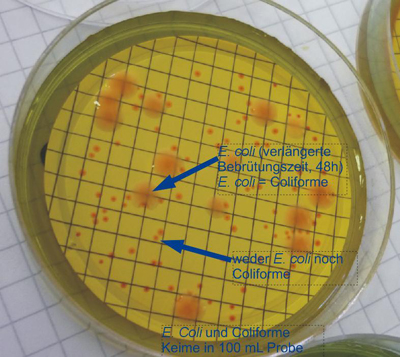
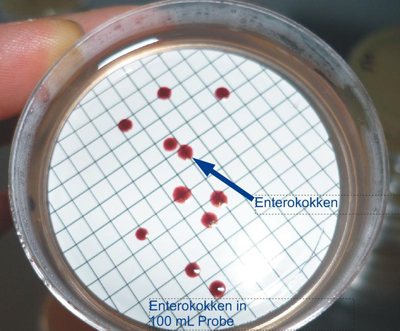
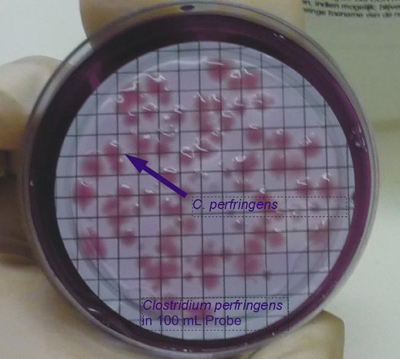

Trinkwasseranalytik - mikrobiologische Parameter:
"Trinkwasser ist das wichtigste Lebensmittel. Es kann nicht ersetzt werden." (Auszug DIN 2000)
"Dem Schutz des Trinkwassers nach Güte und Menge gegenüber konkurrierenden Interessen gebührt der Vorrang. Grund-, Quell- und Oberflächenwasser, das der Trinkwasserversorgung dient, muss daher zum Wohle der Allgemeinheit in bestmöglicher Weise vor Verunreinigung und vor Beeinträchtigung der Ergiebigkeit geschützt werden." (Auszug DIN 2000)
Im Zuge einer routinemäßigen Trinkwasseruntersuchung werden i.d.R. folgende mikrobiologischen Parameter untersucht: Gesamtkeimzahl bei 22°C und 37°C, Escherichia coli, coliforme Keime, Enterokokken, Pseudomonas aeruginosa und Clostridium perfringens.
Doch weshalb werden genau diese Parameter untersucht? Und was kann aus den Resultaten der Untersuchung abgelesen werden?
Gesamtkoloniezahl bei 22°C und 37°C:
Die Gesamtkoloniezahl, sprich die Anzahl der koloniebildenden Einheiten (KBE, kolonieausbildende Bakterien), welche sich in einem Milliliter Wasser befinden und kultiviert werden können, sollte den Wert von 100/mL nicht überschreiten. Dieser Richtwert geht auf Robert Koch zurück: "Wenn ein Filterwerk in jeder Beziehung zufriedenstellend arbeitet, dann finden sich erfahrungsgemäß in filtriertem Wasser weniger als 100 entwicklungsfähige Keime auf 1 cm³". Er stellte anlässlich eines Vergleiches während einer Choleraepidemie fest, dass immer, wenn die Koloniezahl unter 100/mL lag, es zu keiner Epidemie kam.
Die Gesamtkoloniezahl wird bei 22°C und 37°C untersucht, damit psychrophile (ca. 0-28°C, Boden- und Wassertemperatur) sowie mesophile Bakterien (ca. 18-45°C, u.a. Darmbakterien) durch die Methodik erfasst werden können. Die Koloniezahl im Wasser kann erfahrungsgemäß schwanken (Feuerpfeil et al., 2008).
Die Analytik aller möglicher pathogener Keime wäre im Falle einer Trinkwasseruntersuchung zu umfangreich. Zu diesem Zweck werden bei einer Trinkwasseruntersuchung nur ausgewählte Indikatorkeime untersucht, welche auf fäkale Verunreinigungen hinweisen (Auckenthaler et al., 2003).
Escherichia coli:
Escherichia coli ist i.d.R. ein völlig harmloser Bewohner des Darms von warmblütigen Tieren und Menschen. Nur einige Stämme können unter gewissen Bedingungen durchfallartige Erkrankungen hervorrufen. Im Darm können aber auch eine Reihe von pathogenen (krankheitsauslösenden) Keimen vorkommen, welche gemeinsam mit Escherichia coli ausgeschieden werden (Schlegel, 1992; Höll, 1986).
Um nicht für jeden Erreger ein eigenes Verfahren anwenden zu müssen, wird Escherichia coli als Indikator verwendet. Täglich scheidet der Mensch ca. 50 Trillionen Bakterien aus, wovon etwa 1 Trillion Escherichia coli sind. Somit liegt die Wahrscheinlichkeit sehr hoch, eine eventuelle Belastung des Trinkwassers durch pathogene Keime durch die Analytik von Escherichia coli zu erkennen (Klee, 1990).
Coliforme Keime:
Escherichia coli sowie andere Enterobacteriaceae gehört zur Gruppe der coliformen Keime. Der Nachweis von coliformen Keimen kann sowohl auf eine fäkale, als auch auf eine nicht-fäkale Verunreinigung hinweisen. Coliforme Keime vermehren sich dabei nicht im Trinkwasserrohrnetz. Sie können im Trinkwasserverteilungssystem nur ca. 1 bis 2 Wochen überleben. Somit kann davon ausgegangen werden, dass bei einem Nachweis von coliformen Keimen diese kürzlich von außen eingetragen wurden (Schlegel, 1992; Hütter, 1994).
Enterokokken:
Enterokokken sind Fäkalstreptokokken, welche ebenfalls als Fäkalindikatoren dienen. Da sie aber resistenter gegenüber Umwelteinflüssen sind, weisen sie auf länger zurückliegende Verunreinigungen hin (Schlegel, 1992; Hütter, 1994).
Wie man an der Umweltresistenz dieser Fäkalindikatoren unschwer erkennen kann, handelt es sich bei mikrobiologischen Trinkwasseruntersuchungen zumeist um Momentaufnahmen. Die mikrobiologische Zusammensetzung kann sich binnen weniger Tage/Wochen nach einer Verunreinigung schon weitgehend verändern.
Pseudomonas aeruginosa:
Pseudomonas aeruginosa ist aufgrund seiner Anspruchslosigkeit ein in der Umwelt allgegenwärtig (ubiquitär) vorkommender Mikroorganismus. Mit P. aeruginosa infizierte Lebens mittel können jedoch zu Diarrhoe, Lungenentzündung, Meningitis, Hautinfektionen etc. führen.
P. aeruginosa kann sich auch noch bei niederen Temperaturen sowie unter leichtem Nährstoffmangel vermehren. In Trinkwasserversorgungsanlagen kann es hauptsächlich in Filteranlagen (gr. vorhandene Aufwuchsfläche, Ansammlung von Partikeln und somit von Nährstoffen) und Speicherbehältnissen (lange Aufenthaltsdauer) zur Vermehrung von P. aeruginosa kommen.
Da P. aeruginosa ubiquitär vorkommt, kann dieser pathogene Keim durch die Untersuchung auf die zuvor erwähnten fäkalen Indikatorkeime nicht erfasst werden (keine Korrelation). Daher ist die getrennte Bestimmung von P. aeruginosa für die hygienische Beurteilung größerer Anlagen wichtig.
Neben P. aeruginosa ist auch noch P. fluorescens erwähnenswert. P. fluorescens kann ebenfalls sehr häufig aus verunreinigten Wasserproben isoliert werden (Schlegel, 1992; Höll, 1986).

Clostridium perfringens:
Clostridien sind anaerobe sporenbildende Mikroorganismen, welche u.a. In Sedimenten von Seen, in Böden etc. vorkommen. Durch die Entwicklung von Sporen bei Hitze, Austrockung und anderen Umwelteinflüssen sind sie sehr resistent. Bei günstigen Umgebungsbedingungen werden aus den Sporen vegetative Formen, welche sich wieder vermehren können.
Clostridium perfringens kann in Wunden zu einer Gasbrandinfektion und bei Verzehr belasteter Lebensmittel zu einer Vergiftung führen. Das unmittelbare Trinken von Wasser mit geringen Mengen an C. perfringens führt i.d.R. zu keinen Krankheitserscheinungen. Wird das Wasser jedoch zur Herstellung von Lebensmitteln verwendet, überstehen diese Keime das Abkochen (Sporenbildung). Werden diese Lebensmittel nach dem Abkochen eingelagert, so können die Keime anschließend vegetative Formen ausbilden und sich im Lebensmittel vermehren (z.B. Marmelade, Säuglingsnahrung). Werden diese Lebensmittel verzehrt, so werden die Zellen im Magen zerstört, wodurch ein von C. perfringens produziertes Toxin (Gift) freigesetzt wird (Hütter, 1994; Höll, 1986).
Keimreduzierung bei der Trinkwasseraufbereitung:
Oftmals kann bereits eine grundsätzliche Sanierung des Wasservorkommens durch die Errichtung eines Trinkwasserschutzgebietes zu einer Reduktion der Keimzahl führen. Wenn jedoch abzusehen ist, dass diese Maßnahme zu keiner ausreichenden Reduktion führen würde (z.B. Aufenthaltsdauer im Untergrund zu gering - 60-Tages-Grenze nicht erfüllt), können u.a. folgende Desinfektionsverfahren zur Keimreduktion angewandt werden (Gelzhäuser et al., 1985):
Chlorung:
Pro: Kann sowohl punktuell (einmalig) als auch dauerhaft im ganzen System eingesetzt werden, geringe Gefahr der Wiederverkeimung
Contra: Beeinträchtigung von Geschmack, Geruch und chemischer Zusammensetzung des Wassers
Wirkungsweise: Desinfektion durch Oxidation
Bedingung: Chlorzehrung durch andere Wasserinhaltsstoffe gering, ansonsten erhöhte Chlordosierung notwendig
UV-Desinfektion:
Pro: Keine Beeinträchtigung von Geschmack, Geruch und chemischer Zusammensetzung des Wassers, Effektivität mit chemischer Desinfektion dennoch vergleichbar
Contra: Keine Langzeitwirkung (Depotwirkung), daher Möglichkeit der Wiederverkeimung
Wirkungsweise: Inaktivierung der Replikationsmechanismen der Mikroorganismen durch UV-C Strahlung
Bedingung: Rohwasser muss klar sein
Ozonung:
Pro: Keine Beeinträchtigung von Geschmack und Geruch
Contra: Gesundheitlich bedenkliche Reaktionsprodukte
Wirkungsweise: Desinfektion durch Oxidierung
Trinkwasseranalytik - chemisch-physikalische Parameter:
Die nachfolgenden chemisch-physikalischen Parameter werden im Zuge einer routinemäßigen Kontrolle untersucht. Bei Verdacht sind die Proben auf weitere Inhaltsstoffe zu überprüfen (z.B. Arsengehalt bei geogen bedingtem Vorkommen).
Sensorische Parameter:
“Trinkwasser ist Wasser, das [...] geruchlich, geschmacklich und dem Aussehen nach einwandfrei ist.” Aus diesem Grund sind bei Trinkwasserprobenahmen die sensorischen Parameter Geruch, Färbung, Trübung und Geschmack durch den Probenehmer zu überprüfen. Diese sollten für den Verbraucher annehmbar und ohne anormale Veränderungen sein (Österreichisches Lebensmittelbuch).
Temperatur:
Die Wassertemperatur sollte gemäß TWVo nicht über 25°C liegen. Grund- und Quellwasser weist meist Temperaturen zw. 7 - 10°C auf. Starke Temperaturschwankungen bzw. erhöhte Wassertemperaturen können ein Hinweis auf Zuflüsse von Oberflächenwasser sein. Zudem steigt die mikrobiologische Aktivität bei steigenden Wassertemperaturen. Daher können Temperaturen über 10°C bereits Hinweise für den Zufluss von Oberflächenwasser bzw. erhöhte Keimzahlen sein (Klee, 1990; Bundesrecht; Hütter, 1994).
pH:
Liegt der pH-Wert zwischen 6,5 und 9,5, so ist das Wasser in der Regel nicht korrosiv. Der pH-Wert hat zudem auch einen Einfluss auf den Geschmack des Wassers (Österreichisches Lebensmittelbuch).
elektrische Leitfähigkeit:
Die elektrische Leitfähigkeit eines Wassers ermöglicht Rückschlüsse auf dessen Mineralstoffgehalt. Sie sollte möglichst unter 2500 µS/cm liegen, da ansonsten der Mineralstoffgehalt für Trinkwasser zu hoch wäre. Eine zu geringe elektrische Leitfähigkeit weist hingegen auf eine geringe Gesamthärte, eine erhöhte Korrosionswahrscheinlichkeit sowie einen geringen Mineralstoffgehalt hin, was gesundheitliche Folgen nach sich ziehen kann (Hütter, 1994).
Gesamthärte:
Die Gesamthärte ist die Stoffmengenkonzentration an Calcium- und Magnesium-Ionen in mmol/L. Diese Stoffmengenkonzentration wird üblicherweise in °dH (Grad deutscher Härte) umgerechnet. Die Gesamthärte eines Wassers sollte mindestens 8,4°dH betragen. Unter diesem Wert liegt meist eine erhöhte Korrosionswahrscheinlichkeit sowie ein zu geringer Mineralstoffgehalt vor, was gesundheitliche Folgen nach sich ziehen kann (Hütter, 1994).
Oxidierbarkeit:
Die Messung der Oxidierbarkeit dient der Bestimmung der organischen Substanzen im Wasser. Die Oxidierbarkeit von Trinkwasser wird über den Kaliumpermanganatverbrauch der Probe bestimmt. In gewöhnlichen Grundwässern liegt der Kaliumpermanganatverbrauch meist unter 8 mg/L (2 mg/L Permanganatindex). Eine erhöhte Oxidierbarkeit ist ein Hinweis auf mögliche Zuflüsse von Oberflächenwasser (Höll, 1986).
Eisen und Mangan:
Durch die Anwesenheit von Eisen- und Manganverbindungen im Trinkwasser entstehen im Leitungsnetz Inkrustationen und Rohrverschlammungen sowie Ablagerungen. Die Ablagerungen können zu einer beträchtlichen Verengung des Rohrlumens führen. Es gibt eine Reihe von Bakterien (eisenoxidierende Mikroorganismen), welche bei der Anwesenheit von Eisen zu fädigem Wachstum befähigt sind und Biofilme ausbilden. Deren Wachstum wird durch einen Eisengehalt von unter 0,1 mg/L gehemmt (Höll, 1986).
Sulfat:
Mit der Sulfatkonzentration eines Wassers steigt meist auch dessen Betonaggressivität (bei ca. 200 mg/L). Auch gesundheitlich ist eine erhöhte Sulfatkonzentration nicht unerheblich. Schon bei Konzentrationen ab 200 mg/L kann Sulfat zu Darmfunktionsstörungen führen (Höll, 1986).
Chlorid:
Ein erhöhter Chloridgehalt kann sowohl geogen als auch anthropogen bedingt sein. Mögliche anthropogene Einflüssen können die Verunreinigung durch Abwässer, das Ausbringen von Straßenstreusalz oder der Einsatz von Kalidünger sein. Ein erhöhter Chloridgehalt hat keinen nennenswerten physiologischen Einfluss auf den Menschen. Allerdings tritt durch diese Erhöhung ein salzartiger Geschmack auf, welcher die Genießbarkeit des Trinkwassers beeinflusst. Kann ein geogener Ursprung ausgeschlossen werden, so sollten mögliche Zuflüsse von Außen überprüft werden (Hütter, 1994).
Stickstoffverbindungen (Ammonium, Nitrit, Nitrat):
Ammonium ist ein Abbauprodukt organischer Substanzen. Zudem kommt es aber auch in menschlichen und tierischen Exkrementen vor, weshalb eine Erhöhung des Ammoniumgehalts stets als bedenklich gilt.
Nitrit kommt in unverschmutztem Wasser höchstens spurenweise vor. Es entsteht bei natürlichen Ab- und Umbauvorgängen von Ammonium und Nitrat. Eine erhöhte Konzentration ist ein wichtiger Hinweis auf eine Verschmutzung.
Nitrat ist in fast allen Wässern in geringen Mengen nachweisbar und meist unbedenklich. Erhöhte Gehalte können auf eine Verschmutzung hinweisen (Hütter, 1994).
Literaturverzeichnis:
- DIN 2000: Zentrale Trinkwasserversorgung Leitsätze für Anforderungen an Trinkwasser Planung; Bau und Betrieb der Anlagen.
- Schlegel Hans G.: Allgemeine Mikrobiologie. Thieme-Verlag, 7. Überarbeitete Auflage, 1992.
- Klee Otto: Wasser untersuchen. Biologische Arbeitsbücher Quelle & Meyer, 1. Auflage, 1990.
- Auckenthaler Adrian, Huggenberger Peter: Mikroorganismen im Grund- und Trinkwasser - Transport - Nachweismethoden - Wassermanagement. Birkhäuser-Verlag, 1. Auflage, 2003.
- Feuerpfeil Irmgard, Botzenhart Konrad: Hygienisch-mikrobiologische Wasseruntersuchung in der Praxis. Wiley-VCH Verlag, 1. Auflage, 2008.
- Hütter Leonhard A.: Wasser und Wasseruntersuchung. Salle + Sauerländer Verlag, 6. Auflage, 1994.
- Höll Karl: Wasser - Untersuchung, Beurteilung, Aufbereichung, Chemie, Bakteriologie, Virologie, Biologie. de Gruyter Verlag, 7. Auflage, 1986.
- Gelzhäuser P., Bewig F., Holm K., Kryschi R., Reich G., Steuer W.: Desinfektion von Trinkwasser durch UV-Bestrahlung. Expert-Verlag, 1. Auflage, 1985.
- Österreichisches Lebensmittelbuch: Codexkapitel B1, Trinkwasser. 4. Auflage.
- Bundesrecht: Trinkwasserverordnung, BGBl. II Nr. 304/2001 i.d.g.F.